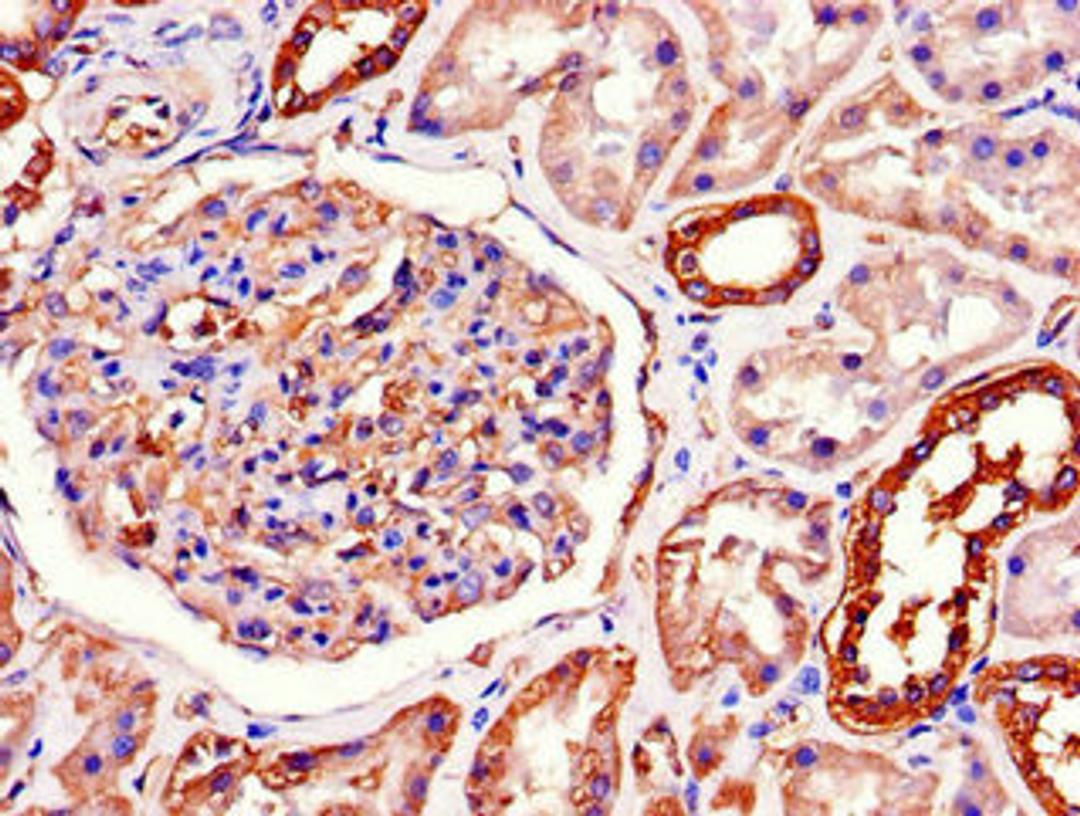
Immunohistochemistry of paraffin-embedded human kidney tissue using CSB-PA18129A0Rb at dilution of 1:100

Product & ReviewsAntibodies
ATP1A1 Antibody
Product Details
- Cat. No.
- CSB-PA18129A0Rb
- Type
- Primary Antibody
- Clonality
- Polyclonal
- Host
- Rabbit

The supplier does not provide quotations for this antibody through SelectScience. You can search for similar antibodies in our Antibody Directory.
Biological Information
- Clonality: Polyclonal
- Host: Rabbit
- Reactivity: Human
- Antigen: Recombinant Human Sodium/potassium-transporting ATPase subunit alpha-1 protein (225-407AA)
- Clone: N/A
- Conjugate: Non-conjugated
- Isotype: IgG
- Modifications: Non-modification
- Source: >95%, Protein G purified
- Gene: P05023
Handling
- Quantity: 100ug
- Storage: Upon receipt, store at -20°C or -80°C. Avoid repeated freeze.
- Buffer: Preservative: 0.03% Proclin 300<br />Constituents: 50% Glycerol, 0.01M PBS, PH 7.4
Applications
- ELISA (ELISA)
- Immunohistochemistry (IHC)
- Immunofluorescence (IF)